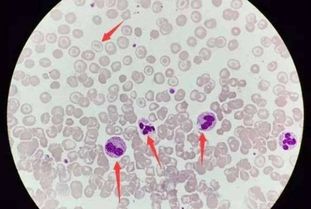
嗜酸性粒细胞偏高，健康警报还是虚惊一场？

在现代医学的检测中,血液检查是评估个体健康状况的重要手段之一,嗜酸性粒细胞(Eosinophils)作为白细胞的一种,其数量的变化往往能反映身体的某些病理变化,当血液报告中显示嗜酸性粒细胞偏高时,许多人可能会感到困惑和担忧,本文将深入探讨嗜酸性粒细胞偏高的含义、可能的原因以及应对策略。
嗜酸性粒细胞的生理作用
嗜酸性粒细胞是免疫系统的一部分,它们在对抗寄生虫感染和过敏反应中扮演着重要角色,正常情况下,嗜酸性粒细胞占白细胞总数的1%至6%,当身体受到某些刺激时,嗜酸性粒细胞的数量可能会增加,以应对外来的威胁。
嗜酸性粒细胞偏高的可能原因
1、过敏性疾病:过敏反应是导致嗜酸性粒细胞增多的常见原因,包括花粉热、食物过敏、药物过敏等。
2、寄生虫感染:某些寄生虫感染,如蛔虫、钩虫等,会刺激嗜酸性粒细胞的产生。
3、皮肤病:如湿疹、银屑病等皮肤病,也可能导致嗜酸性粒细胞数量增加。
4、自身免疫性疾病:如系统性红斑狼疮(SLE)等,可能会引起嗜酸性粒细胞的增多。
5、肿瘤:某些类型的肿瘤,尤其是淋巴瘤,可能会导致嗜酸性粒细胞的异常增多。
6、其他因素:包括某些药物、应激状态、剧烈运动等也可能引起嗜酸性粒细胞的暂时性升高。
嗜酸性粒细胞偏高的健康影响
嗜酸性粒细胞偏高本身并不一定意味着严重的健康问题,但它可能是身体发出的警报信号,如果嗜酸性粒细胞的增多与特定的疾病相关,那么及时的诊断和治疗就显得尤为重要,长期的嗜酸性粒细胞增多可能会导致组织损伤,影响器官功能。
如何应对嗜酸性粒细胞偏高
1、咨询医生:应该咨询医生,了解自己的嗜酸性粒细胞偏高是否需要进一步的检查和治疗。
2、详细检查:根据医生的建议,可能需要进行更详细的检查,如过敏原测试、寄生虫检查、影像学检查等,以确定嗜酸性粒细胞增多的具体原因。
3、生活方式调整:如果嗜酸性粒细胞的增多与过敏或应激有关,那么调整生活方式,如避免过敏原、减少压力等,可能会有所帮助。
4、药物治疗:在某些情况下,医生可能会开具抗过敏药物、抗寄生虫药物或免疫抑制剂等,以控制嗜酸性粒细胞的数量。
5、定期监测:即使嗜酸性粒细胞偏高的原因已经明确,也需要定期监测其数量,以评估治疗效果和调整治疗方案。
嗜酸性粒细胞偏高可能是多种因素的结果,它既可以是身体对某些刺激的正常反应,也可能是某些疾病的早期信号,面对嗜酸性粒细胞偏高的血液报告,最重要的是保持冷静,及时咨询医生,并根据医生的建议进行相应的检查和治疗,通过科学的方法,我们可以更好地理解嗜酸性粒细胞偏高的含义,并采取适当的措施来维护我们的健康。
这篇文章是一个示例,旨在提供一个关于嗜酸性粒细胞偏高的概述,在实际情况中,个体的健康状况和嗜酸性粒细胞偏高的具体原因可能需要医生的专业评估和诊断。








